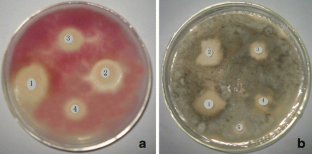

Abstract
A novel mannan-specific lectin was isolated from the roots of a traditional Chinese herbal medicine, Ophioglossum pedunculosum through ion-exchange chromatography and gel filtration. With a molecular mass of 19,835.7 Da demonstrated by MALDI-TOF analysis, this novel agglutinin was designated as O. pedunculosum agglutinin (OPA), specifically agglutinating human O erythrocytes and rabbit erythrocytes. The hemagglutination could be strongly inhibited by mannan and thyroglobulin, the activity of which was stable in pH range of 4.0–8.0 and at temperatures below 50 °C. Chemical modification studies indicated that tryptophan and arginine residues were essential for its hemagglutinating activity. Meanwhile, it showed antifungal activities toward Sclerotium rolfsii and Fusarium graminearum. In addition, to amplify cDNA of OPA by 3′/5′-rapid amplification of cDNA ends (RACE), the N-terminal 30 amino acids sequence of OPA was determined, and degenerate primers were designed. The obtained full-length cDNA of OPA contained 885 bp with an open-reading frame of 600 bp encoding a precursor protein of 199 amino acids, while the mature protein had 170 amino acids.

Similar content being viewed by others
References
Suseelan, K. N., Mitra, R., Pandey, R., Sainis, K. B., & Krishna, T. G. (2002). Archives of Biochemistry and Biophysics, 407, 241–247.
Ciopraga, J., Gozia, O., Tudor, R., Brezuica, L., & Doyle, R. (1999). Biochimica et Biophysica Acta, 1428, 424–432.
Rüdiger, H. (1997). In H. J. Gabius & S. Gabiu (Eds.), Glycosciences: status and perpectives, Chap. 23: Structure and function of plant lectins (pp. 415–438). Weinheim: Chapman & Hall.
Rüdiger, H. (1998). Acta Anatomica, 161, 130–152.
Guzmán-Partida, A. M., Robles-Burgueño, M. R., Ortega-Nieblas, M., & Vázquez-Moreno, I. (2004). Biochimie, 86, 335–342.
Sharon, N., & Lis, H. (1972). Science, 177, 949–959.
Liu, B., Bian, H. J., & Bao, J. K. (2010). Cancer Letters, 287, 1–12.
Van Damme, E. J. M., Lannoo, N., & Peumans, W. J. (2008). In J. C. Kader & M. Delseny (Eds.), Advances in botanical research, lant lectins (vol. 48, pp. 107–209). San Diego: Elsevier Science.
Lis, H., & Sharon, N. (1986). Annual Review of Biochemistry, 55, 35–67.
Moreira, R. A., Ainouz, I. L., Oliveira, J. T. A., & Cavada, B. S. (1991). Memórias do Instituto Oswaldo Cruz, 86, 211–218.
Utarabhand, P., & Akkayanont, P. (1995). Phytochemistry, 38, 281–285.
Sharon, N., & Lis, H. (1989). Lectins (1st ed.). London: Chapman & Hall.
Brandley, B. K., Swiedler, S. J., & Robbins, P. W. (1990). Cell, 63, 861–863.
Barral Netto, M., Santos, S. B., Barral, A., Moreira, L. I. M., Santos, C. F., Moreira, R. A., et al. (1992). Immunological Investigations, 21, 297–303.
Konozy, E. H. E., Mulay, R., Faca, V., Ward, R. J., Greene, L. J., Roque-Barriera, M. C., et al. (2002). Biochimie, 84, 1035–1043.
Peumans, W. J., & Van Damme, E. J. M. (1995). Plant Physiology, 109, 347–352.
Liu, Q. H., Wang, H. X., & Ng, T. B. (2004). Peptides, 25, 7–10.
Wang, H., Gao, J., & Ng, T. B. (2000). Biochemical and Biophysical Research Communications, 275, 810–816.
Weis, W. I., & Drickamer, K. (1996). Annual Review of Biochemistry, 65, 441–473.
Dombrovska, O., & Qiu, Y. L. (2004). Molecular Phylogenetics and Evolution, 32, 246–263.
Hauk, W. D., Parks, C. R., & Chase, M. W. (2003). Molecular Phylogenetics and Evolution, 28, 131–151.
Kramer, K. U., & Green, P. S. (1990). In K Kubitzki (Ed.), The families and genera of vascular plants, vol. I: Pteridophytes and gymnosperms (pp. 193–197). Berlin, Heidelberg: Springer-Verlag.
Wu, S. H., Luo, X. D., Ma, Y. B., Hao, X. J., & Wu, D. G. (2002). Acta Pharmacologica Sinica, 37, 33–36.
Laemmli, U. K. (1970). Nature, 227, 680–685.
Andrew, P. (1970). Methods of Biochemical Analysis, 18, 1–6.
Laremore, T. N., Zhang, F., & Linhardt, R. J. (2007). Analytical Chemistry, 79, 1604–1610.
Lam, S. S., Wang, H., & Ng, T. B. (1998). Biochemical and Biophysical Research Communications, 253, 135–142.
Wang, H. X., Ng, T. B., Liu, W. K., Ooi, V. E. C., & Chang, S. T. (1995). International Journal of Peptide and Protein Research, 46, 508–513.
Spande, T. F., & Witkop, B. (1967). Methods in Enzymology, 11, 498–506.
Komath, S. S., Nadimpalli, S. K., & Swamy, M. J. (1998). Biochemisty and Molecular Biology International, 44, 107–116.
Laszlo, P., & Smith, E. L. (1975). The Journal of Biological Chemistry, 25, 557–564.
Gao, S., An, J., Wu, C. F., Gu, Y., Chen, F., Yu, Y., et al. (2005). Acta Biochimica et Biophyica Sinica, 37, 47–54.
Ye, X. Y., Ng, T. B., Tsang, P. W. K., & Wang, J. (2001). Journal of Protein Chemistry, 20, 367–375.
Lam, S. K., & Ng, T. B. (2001). Archives of Biochemistry and Biophysics, 393, 271–280.
Mellor, R. B., Gadd, G. M., Rowell, P., & Stewart, W. D. P. (1981). Biochemical and Biophysical Research Communications, 99, 1348–1353.
McCowen, S. M., MacArthur, L., & Gates, J. E. (1987). Current Microbiology, 14, 329–333.
Tateno, H., Winter, H. C., Petryniak, J., & Goldstein, I. J. (2003). The Journal of Biological Chemistry, 278, 10891–10899.
Yu, P., Liu, Y. R., & Zheng, Y. (2004). Chinese Journal of Applied and Environmental Biology, 10, 740–744.
Yu, P., Liu, Y. R., & Zheng, Y. (2003). Journal of Plant Resources and Environment, 12, 6–9.
Liu, Y. R., Yu, P., & Zheng, Y. (2003). Journal of Plant Physiology, 39, 647–650.
Yu, P., Zheng, Y., & Liu, Y. R. (2004). Journal of Tropical and Subtropical Botany, 12, 57–62.
Percudani, R., Montanini, B., & Ottonello, S. (2005). Proteins: Structure, Function, and Bioinformatics, 60, 670–678.
Banerjee, N., Sengupta, S., Roy, A., Ghosh, P., Das, K., & Das, S. (2011). PloS One, 6, e18593.
Gaidamashvili, M., Ohizumi, Y., Iijima, S., Takayama, T., Ogawa, T., & Muramoto, K. (2004). The Journal of Biological Chemistry, 279, 26028–26035.
Mo, H., Rice, K. G., Evers, D. L., Winter, H. C., Peumans, W. J., Damme, E. J. M. V., et al. (1999). The Journal of Biological Chemistry, 274, 33300–33305.
Yoshima, H., Matsumoto, A., Mizuochi, T., Kawasaki, T., & Kobata, A. (1981). The Journal of Biological Chemistry, 256, 8476–8484.
Liu, C., Zhao, X., Xu, X. C., Li, L. R., Liu, Y. H., Zhong, S. D., et al. (2008). International Journal of Biological Macromolecules, 42, 138–144.
Devyani, N., & Mala, R. (1998). Biochemical and Biophysical Research Communications, 249, 207–212.
Li, Y. R., Liu, Q. H., Wang, H. X., & Ng, T. B. (2008). Biochimica et Biophysica Acta, 1780, 51–57.
Bowman, S. M., & Free, S. J. (2006). Bioassays, 28, 799–808.
Kim, Y., Nandakumar, M. P., & Marten, M. R. (2007). Trends in Biotechnology, 25, 395–400.
Koharudin, L., Viscomi, A., Jee, J., Ottonello, S., & Gronenborn, A. (2008). Structure, 16, 570–584.
Acknowledgements
This work was supported by grants from the National Key Science and Technology Projects Fund (2009ZX8009-072B), the National Natural Science Foundation of China (General Programs: Nos. 30670469 and 30970643). We gratefully acknowledge the contribution and enthusiasm of our coworkers and collaborators in our laboratories in the course of this investigation.
Author information
Authors and Affiliations
Corresponding author
Additional information
Xue-mei He and Na Ji contributed equally to this work
Rights and permissions
About this article
Cite this article
He, Xm., Ji, N., Xiang, Xc. et al. Purification, Characterization, and Molecular Cloning of a Novel Antifungal Lectin From the Roots of Ophioglossum pedunculosum . Appl Biochem Biotechnol 165, 1458–1472 (2011). https://doi.org/10.1007/s12010-011-9367-z
Received:
Accepted:
Published:
Issue Date:
DOI: https://doi.org/10.1007/s12010-011-9367-z




